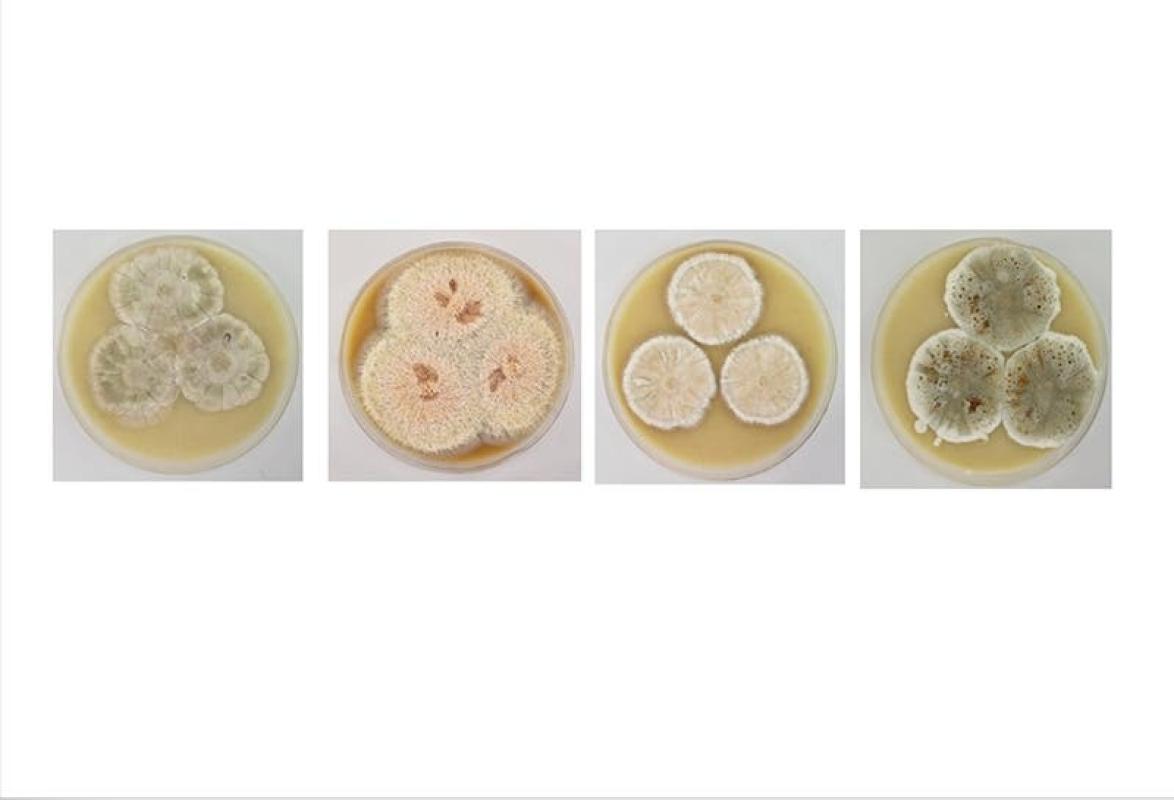

Científicos descubrieron cuatro nuevas especies de hongos en la Antártica
Científicos descubrieron cuatro nuevas especies de hongos en la Antártica
Científicos descubrieron cuatro nuevas especies de hongos en la Antártica
T13 En Vivo
Más de una década atrás, en 2010, un equipo de científicos de las universidades de Chile y de Santiago, junto al Instituto Canario de Investigaciones Agrarias, realizó una expedición a la Antártica para, entre otras cosas, recoger muestras de diferentes hongos que se encontraban en el continente blanco.
Grande fue la sorpresa de los científicos cuando al analizar la colección se dieron cuenta de que “un 75 por ciento de los hongos que íbamos aislando no los podíamos encontrar en nuestra base de datos, y no podíamos clasificarlos a nivel de género”, recordó Inmaculada Vaca, profesora del Departamento de Química de la Facultad de Ciencias.

Minsal: Chile superó los 14 millones de personas con esquema completo de vacunación contra COVID-19
La académica agrega que, al estar trabajando en la parte taxonómica, “salió en 2014 un artículo de hongos del Hemisferio Norte donde se describían nuevas especies. Comenzó a haber más datos genómicos y nos dimos cuenta que estos hongos que no habíamos podido clasificar pertenecían al género Pseudogymnoascus”.
Lo particular de este descubrimiento es que, hasta el momento, no existen registros de hongos de esta familia en el Hemisferio Sur, mucho menos en la Antártica.
“Es muy importante porque estamos haciendo las primeras descripciones de estas especies, y todo apunta a que hay especies nuevas de este género que son endémicas de la Antártica, y es todo un logro por la poca información que había al principio. Con nuestro aporte se abre la posibilidad para describir muchas especies de este género que debe haber por seguro allá”.
La profesora Vaca destacó que el lograr una descripción detallada de estas especies permite conocer mejor la biodiversidad fúngica del continente blanco, y -por lo tanto- tomar medidas eficaces para conservarla, y con ella también al ecosistema antártico en su conjunto.
“Los hongos tienen la particularidad de que son regeneradores de las fuentes primarias de materia orgánica, entonces son fundamentales porque permiten que otros microorganismos puedan alimentarse. Toda la materia orgánica que otros organismos no pueden digerir, ellos hacen que pueda ser absorbible”, aseguró la académica, que además recordó que muchos ecosistemas se destruyen por perder la microbiota que tienen, lo que hace que los suelos pierdan sus nutrientes.









